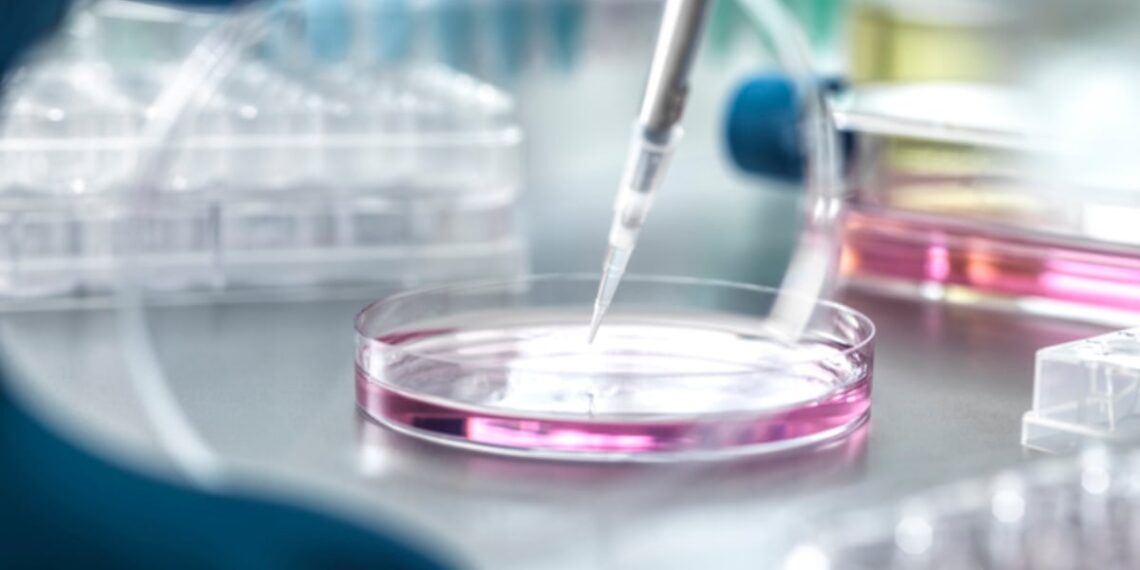

A randomized, double-blind, placebo-controlled medical trial in South Korea has discovered that day by day low-molecular-weight collagen peptides improved a number of indicators of pores and skin ageing in wholesome adults inside eight weeks, with advantages that lasted two weeks after stopping.
The research, carried out by researchers on the Korea Institute of Academic Facility Security and Nongshim Co., Ltd., enrolled 70 adults aged 20 to 59 and examined a branded ingredient, NS Collagen Peptide, at 1,650mg per day.
Those that took collagen confirmed fewer wrinkles that improved over time. For example, crow’s toes across the eyes have been noticed to be shallower by day 10.

A six-month medical trial by Pusan Nationwide College has discovered that taking 3,000mg of low-molecular-weight collagen peptides (LMCP) day by day helped scale back knee ache and enhance motion in adults with early knee osteoarthritis.
A complete of 80 adults aged 40 to 75 and had gentle osteoarthritis have been randomized to take both collagen peptides or placebo day by day for 180 days.
After six months, contributors who took collagen peptides had considerably much less knee ache than those that took the placebo. On common, WOMAC ache scores dropped by 1.9 factors within the collagen group however elevated by 0.6 factors within the placebo group.

A 12-week randomized trial by the Nationwide College of Singapore (NUS) has discovered that day by day 5-hydroxytryptophan (5-HTP) supplementation modestly improved a worldwide cognitive check and decreased depressive signs in community-dwelling older adults.
The intervention additionally raised blood serotonin, the neurotransmitter 5-HTP helps produce. Nonetheless, anxiousness scores and Alzheimer’s-linked blood proteins didn’t change.
A complete of 30 adults with a imply age of 66 to 67 have been randomized to take both 100mg 5-HTP nightly or placebo.

The Nationwide College of Singapore’s (NUS) medical faculty has opened a brand new medical trial heart in its bid to drive analysis within the rising area of wholesome longevity and geromedicine.
Abbott Diet, Danone, Haleon, and L’Oreal are a few of the business companions that the centre is working with.
“Getting old is likely one of the best challenges confronting the world immediately. Whereas Singaporeans live longer, the final 10 years of life are sometimes spent in ailing well being,” stated Professor Chong Yap Seng, dean, NUS Medication.

Nicotinamide mononucleotide (NMN) has gained traction as an anti-aging ingredient, however a 12-week research funded by Mitsubishi Company Life Sciences – stated to be “first of its type” human medical trial – confirmed that it may enhance hair well being too.
A key discovering was that NMN supplementation has led to a big improve in hair size development on the anagen section, primarily based on TrichoScan evaluation.
Terminal hair density three days after shaving additionally elevated considerably from 38.6 ± 33.7 to 66.2 ± 15.1hairs/cm2.